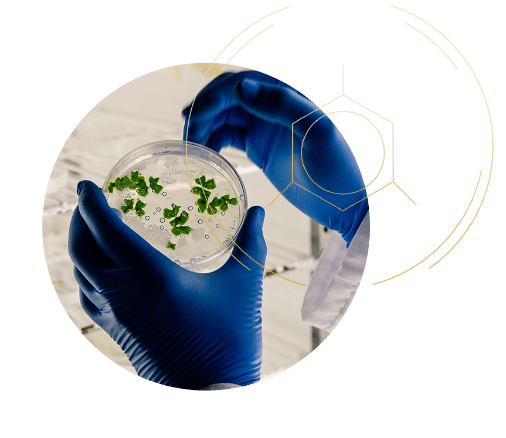

From challenges to advantages: Agrinetica's five game-changing CRISPR 2.0 solutions transform the peanut industry's biggest challenges into revolutionary opportunities in a $100 billion annual market.

Peanut allergies affect tens of millions of children and adults worldwide, with cases rising dramatically every year. Beyond the individuals directly affected, this crisis impacts hundreds of millions more – parents living in constant fear, schools forced to ban peanuts entirely, airlines restricting food options, and manufacturers limiting product innovation.
The ripple effects are staggering: operational chaos in educational institutions, restricted food choices in public spaces, and billions in annual economic losses in the United States alone. For those with severe allergies, even trace exposure can trigger potentially fatal anaphylactic shock – one of the most dangerous food-related reactions known to medicine.
Using CRISPR 2.0 technology, Agrinetica has successfully developed reduced-allergen peanuts that maintain full nutritional value, demonstrating that addressing the allergy crisis is not a distant dream – it’s happening now.
Our approach targets the root cause by removing specific allergenic proteins in the peanut, aiming to dramatically reduce the risk of severe reactions while preserving yield and agronomic performance. This has the potential to transform life for millions of allergy sufferers, open the door to easing institutional bans, and unlock vast new market opportunities.
Fatty acid oxidation devastates the peanut industry, causing billions in annual losses
from spoilage, shortened shelf-life, product returns and lower quality food ingredients.
The oxidation process creates rancid, bitter flavors that ruin consumer experience
and brand reputation. While peanuts offer rich nutrition, their unsaturated fatty acids
make them highly susceptible to oxidation – also potentially increasing risks of inflammation,
cardiovascular disease, and even cancer when consumed in oxidized form.
Through CRISPR 2.0 editing, Agrinetica is revolutionizing peanut fatty acid composition to deliver what the food industry has sought for decades: dramatically enhanced quality, stability and extended shelf-life.
Our modified peanuts will maintain better taste and freshness months longer, reduce waste throughout the supply chain, and enable new product formulations with superior texture, consistency, and resistance to separation – transforming both profitability and product quality across the industry.
Global peanut production loses up to 30% of potential yields annually – billions of dollars in lost value due to asynchronous maturation: Even when farmers harvest peanuts at peak overall yield, plants still carry pods at very different stages of development – some over-mature and already starting to rot, others still immature and not fully developed. This built-in maturity gap can drive harvest losses of up to 30%.
By applying CRISPR 2.0, Agrinetica enables synchronized pod development – ensuring all pods mature simultaneously for optimal harvest timing.
This single innovation delivers multiple benefits:
Maximized harvest efficiency:
All pods ready at once means no compromise between early and late maturation
Dramatic loss reduction:
Targeting up to 30% of losses linked to poor timing alone
Enhanced mechanization:
Uniform maturity enables precise, efficient mechanical harvesting
Improved farmer economics:
Higher yields and lower costs transform profitability
Aflatoxins – deadly carcinogens produced by Aspergillus fungi – represent one of agriculture’s most serious health threats. The WHO strictly regulates these toxins because they cause liver cancer, suppress immune function, and stunt children’s growth.
Peanuts are particularly vulnerable: hot, humid growing conditions create perfect fungal breeding grounds, while traditional asynchronous harvesting leaves pods in soil at varying moisture levels – ideal for toxin production. In the U.S up to 30% of finished lots of shelled peanuts exceed the edible limit of 15 ppb total aflatoxin.
Our CRISPR 2.0-enabled uniform pod maturation is designed to significantly reduce the primary conditions for aflatoxin development. When all pods mature simultaneously:
Harvest timing becomes precise, avoiding the moisture variations that promote fungal growth
No pods remain in soil past optimal harvest, preventing rot and fungal colonization
Post-harvest handling becomes standardized, reducing contamination risks throughout processing
This integrated approach doesn’t just reduce aflatoxin – it fundamentally restructures the production system to prevent contamination before it begins.
Climate change threatens 40% of global peanut-growing regions, with drought and extreme weather potentially destroying billions in crop value annually. Stressed plants become magnets for diseases and pests, while nutrient uptake crashes, creating a cascade of failure.
Agrinetica’s proprietary ROP9 trait, developed through CRISPR 2.0, delivers unprecedented drought resistance that protects yields even under severe water stress. This trait:
Targets improved productivity across drought-vulnerable growing regions that account for up to 40% of global peanut production
Reduces disease susceptibility by keeping plants vigorous under stress
Ensures nutrient uptake continues during drought conditions
Provides climate resilience essential for long-term food security
These five interconnected solutions don’t just solve problems – they revolutionize an entire industry. Together, they position Agrinetica to transform the $100 billion annual peanut market while improving food safety and security for hundreds of millions worldwide.
From eliminating the fear of allergic reactions to securing yields against climate change, from extending shelf-life to preventing toxic contamination – we’re not just creating better peanuts. We’re creating the future of food.
